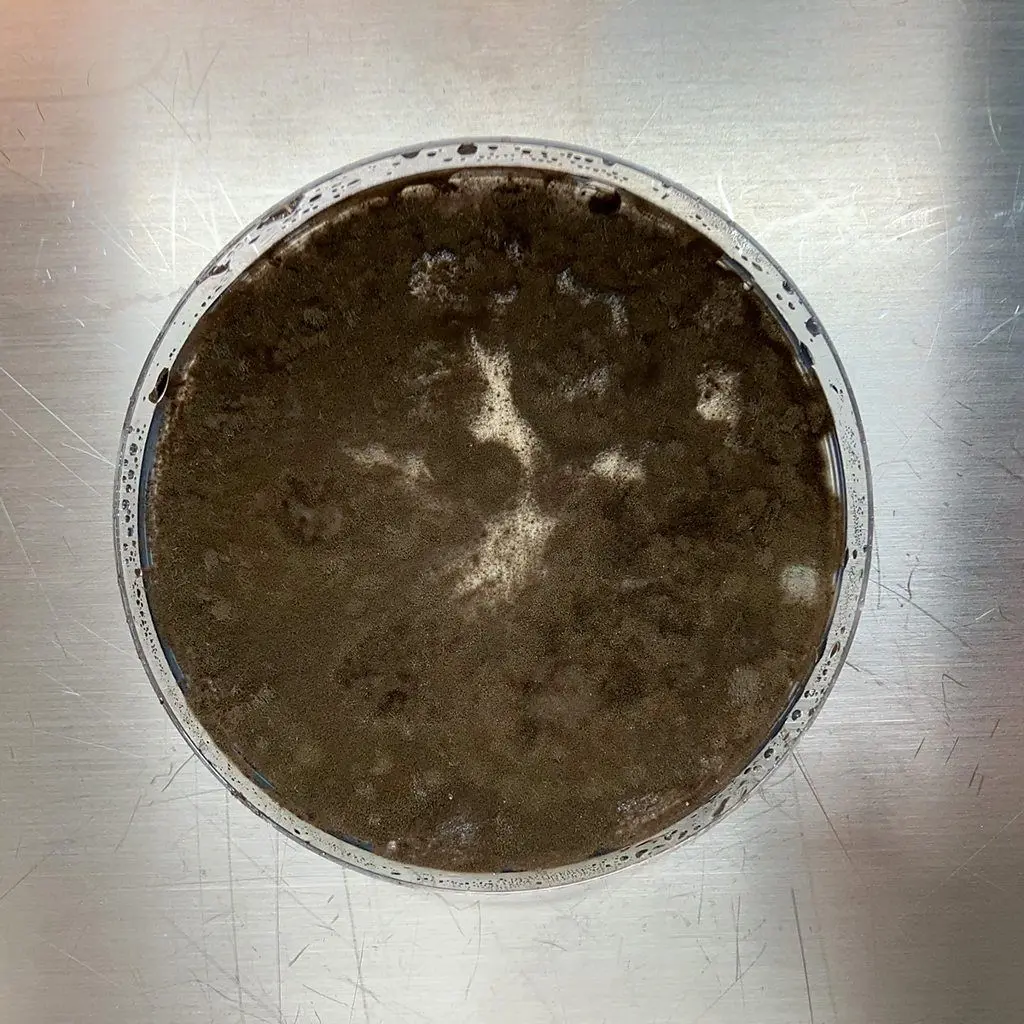
Cladosporium sphaerospermum           ӡ

غموض يحيط عفناً أسود يحتمل أنه "يتغذى" على الإشعاع في مفاعل تشيرنوبل النووي

عُثر على نوع من العفن في موقع كارثة تشيرنوبل النووية يُرجح أنه يتغذى على الإشعاع. فهل يمكن استخدامه لحماية رواد الفضاء من الأشعة الكونية؟
في مايو/أيار عام 1997، دخلت نيللي زهدانوفا أحد أكثر الأماكن إشعاعاً على وجه الأرض - أطلال محطة تشيرنوبل النووية المنفجرة والمهجورة - لتكتشف أنها لم تكن وحدها هناك.
فعلى امتداد الأسقف والجدران وداخل القنوات المعدنيّة التي تحمي الكابلات الكهربائية، استوطن العفن الأسود في مكان كان يُعتقد يوماً ما أنه غير صالح للحياة.
وفي الحقول والغابات المحيطة، عادت أعداد الذئاب والخنازير البريّة إلى الزيادة في غياب البشر. ومع ذلك، ما زالت هناك حتى اليوم مناطق تُسجّل مستويات كبيرة من الإشعاع، نتيجة تطاير مواد من المفاعل أثناء انفجاره.
وكان العفن - المكون من عدة أنواع من الفطريات - يظهر سلوكاً مثيراً للاهتمام. فلم يكن وجوده في هذا المكان مجرد نتيجة لرحيل العاملين عن المحطة وتركها مهجورة، بل إن نيللي زهدانوفا كانت قد اكتشفت في دراسات سابقة لتربة تشيرنوبل، أن هذه الفطريات تنمو متجهة نحو الجزيئات المشعة المنتشرة في المنطقة.
- الأعداد الحقيقية لضحايا انفجار مفاعل تشيرنوبل النووي
- تسريبات نووية هزّت العالم: من تشيرنوبل إلى فوكوشيما
والآن، اكتشفت أنها وصلت بالفعل إلى المصدر الأصلي للإشعاع، أي الغرف داخل مبنى المفاعل المنفجر.
ومع كل دراسة كان العفن يقترب فيها من مستويات إشعاع ضارة، قلبت أبحاث زهدانوفا مفاهيمنا حول تأثير الإشعاع على الحياة على الأرض رأساً على عقب.
واليوم، يفتح اكتشافها باباً للأمل في إمكانية تنظيف المواقع الملوثة بالإشعاع، بل وقد يوفر أيضاً وسائل لحماية رواد الفضاء من الإشعاع الضار أثناء رحلاتهم في الفضاء.
وقبل أحد عشر عاماً من زيارة زهدانوفا، تحول اختبار روتيني للسلامة في المفاعل الرابع بمحطة تشيرنوبل النووية إلى أسوأ كارثة نووية في التاريخ.
فقد أدت سلسلة من الأخطاء في تصميم المفاعل وتشغيله إلى انفجار هائل في الساعات الأولى من يوم 26 أبريل/ نيسان 1986. وأسفر ذلك عن إطلاق ضخم ومفاجئ للمواد المشعة.
وكان اليود المشع سبباً رئيسياً في حالات الوفاة خلال الأيام والأسابيع الأولى، ثم أصبح لاحقاً أحد أبرز مسببات الإصابة بالسرطان.
وفي محاولة للحد من خطر التسمم الإشعاعي والمضاعفات الصحية طويلة الأمد، تم إنشاء منطقة عزل بقطر 30 كيلومتراً تُعرف باسم "منطقة الإقصاء" لإبقاء الناس بعيداً عن أخطر بقايا المفاعل الرابع المشعة.
لكن بينما جرى إبعاد البشر، كان العفن الأسود الذي رصدته زهدانوفا يتمدد ببطء ليستوطن المنطقة.
ومثلما تمتد النباتات نحو ضوء الشمس، أشارت أبحاث زهدانوفا إلى أن الخيوط الفطرية للعفن الأسود تبدو وكأنها تنجذب إلى الإشعاع المؤيّن.
غير أن ما أسمته زهدانوفا بـ "الانجذاب الإشعاعي" كان مفارقة لافتة؛ فالإشعاع المؤيّن أقوى بكثير من ضوء الشمس، إذ يُطلق وابلاً من الجسيمات المشعة التي تمزّق الحمض النووي والبروتينات كما تخترق الرصاصات الأجساد.
ويمكن أن يؤدي هذا الضرر إلى طفرات خطيرة، ويدمّر الخلايا، بل وقد يقتل الكائنات الحية.
إلى جانب الفطريات التي بدت منجذبة للإشعاع، كشفت دراسات زهدانوفا عن وجود 36 نوعاً آخر من الفطريات العادية، وإن كانت بعيدة الصلة، تنمو في محيط تشيرنوبل.
وعلى مدى العقدين التاليين، امتد أثر عملها الريادي على هذه الفطريات إلى ما هو أبعد من أوكرانيا، مضيفاً اكتشافات علمية جديدة حول أساس محتمل لنمط حياة مختلف على الأرض، حياة لا تعتمد على ضوء الشمس، بل تزدهر بالإشعاع.
ودفع هذا الاكتشاف علماء ناسا إلى التفكير في إمكانية إحاطة رواد الفضاء بجدران من الفطريات لتوفير نمط قوي من أنظمة دعم الحياة.
في قلب هذه القصة، هناك أصباغ واسعة الانتشار في الكائنات الحية على الأرض: ينتجها جزيء يُسمى "الميلانين"، الذي تتدرج ألوانه من الأسود إلى البني المائل إلى الحُمرة، وهو المسؤول عن اختلاف ألوان البشرة والشعر لدى البشر.
لكنه أيضاً السبب وراء اللون الأسود للفطريات التي نمت في تشيرنوبل، إذ كانت جدران خلاياها مشبعة بالميلانين.
تماماً كما تحمي البشرة الداكنة خلايانا من الأشعة فوق البنفسجية، اشتبهت زهدانوفا في أن الميلانين الموجود في هذه الفطريات يعمل كدرعٍ واقٍ ضد الإشعاع المؤين.
- تسريبات نووية هزّت العالم: من تشيرنوبل إلى فوكوشيما
- تسرب مياه مشعة من محطة طاقة نووية بولاية مينيسوتا الأمريكية
لم تكن الفطريات وحدها هي التي استفادت من الخصائص الوقائية للميلانين.
ففي البرك المحيطة بتشيرنوبل، كانت الضفادع التي تحتوي خلاياها على تركيزات أعلى من الميلانين – وبالتالي أكثر قتامة في اللون – أقدر على البقاء والتكاثر، مما أدى تدريجياً إلى تحول المجموعات المحلية هناك إلى اللون الأسود.
وأثناء الحروب، قد يحمي الدرع الجندي من السهم عبر انحرافه بعيداً عن جسده. لكن الميلانين لا يعمل بهذه الطريقة؛ فهو ليس سطحاً صلباً أو أملس.
فالإشعاع – سواء كان فوق بنفسجي أو جسيمات مشعة – يُمتَص داخل بنيته غير المنتظمة، إذ تتبدد طاقته بدلاً من أن تنحرف.
كما أن الميلانين يعمل كمضاد للأكسدة، إذ يستطيع تحويل الأيونات النشطة التي يولدها الإشعاع في المادة الحيوية وإعادتها إلى حالة مستقرة.
وفي عام 2007، أضافت إيكاترينا داداتشوفا، العالمة النووية في كلية طب ألبرت آينشتاين بنيويورك، إلى أبحاث زهدانوفا حول فطريات تشيرنوبل، كاشفة أن نموها لم يكن موجهاً نحو الإشعاع فقط (انجذاب إشعاعي) بل إنه ازداد بالفعل في وجوده.

واكتشفت داداتشوفا أن الفطريات المحتوية على الميلانين – مثل تلك الموجودة داخل مفاعل تشيرنوبل – ازداد نموها بنحو 10 في المئة، إذ كانت أسرع في النمو عند تعرضها لعنصر السيزيوم المشع مقارنة بالفطريات نفسها التي لم تتعرض للإشعاع.
كما اكتشفت هي وفريقها البحثي أن هذه الفطريات المعرضة للإشعاع بدت وكأنها تستخدم الطاقة لدعم عملياتها الأيضية. وبعبارة أخرى، كانت تستغل الإشعاع لتحقيق النمو.
وكانت زهدانوفا قد رجّحت أن هذه الفطريات قد تكون قادرة على استغلال الطاقة المنبعثة من الإشعاع، وجاءت أبحاث داداتشوفا لتبني على هذا الطرح أيضاً.
فلم تكن الفطريات تنمو باتجاه الإشعاع طلباً للدفء أو نتيجة تفاعل مجهول بينه وبين البيئة المحيطة كما افترضت زهدانوفا، بل لأنها تتغذى فعلياً على طاقة الإشعاع نفسه، وفقاً لداداتشوفا.
وأطلقت العالمة الأمريكية على هذه العملية اسم "التخليق الإشعاعي"، وكان الميلانين العنصر المحوري في هذه النظرية.
وقالت داداتشوفا: "طاقة الإشعاع المؤين تزيد بنحو مليون مرة عن طاقة الضوء الأبيض المستخدم في عملية التمثيل الضوئي.
لذلك نحتاج إلى محوِل طاقة شديد القوة، ونعتقد أن الميلانين قادر على أداء هذا الدور، بتحويل الإشعاع المؤين إلى مستويات من الطاقة قابلة للاستخدام".
ولا يزال التخليقالإشعاعي مجرد نظرية، إذ لا يمكن إثباتها إلا إذا تم اكتشاف الآلية الدقيقة التي تربط بين الميلانين والتمثيل الغذائي.
ويحتاج العلماء إلى تحديد المسار المستقبلي – أو موقع بعينه داخل البنية المعقدة للميلانين – المسؤول عن تحويل الإشعاع إلى طاقة تُستخدم في النمو.
- "الدم الذهبي": تعرّف على سحر فصيلة الدم الأندر في العالم
- الذكاء الاصطناعي يساعد الأطباء في العثور على الكسور وعلاجها
وفي السنوات الأخيرة، بدأت داداتشوفا وزملاؤها في تحديد بعض المسارات والبروتينات التي قد تفسر زيادة نمو الفطريات عند تعرضها للإشعاع المؤين.
ولا تظهر جميع الفطريات التي تحتوي على الميلانين ميلاً للانجذاب الإشعاعي أو نمواً إيجابياً في وجود الإشعاع.
فعلى سبيل المثال، كشفت دراسة أجرتها زهدانوفا وزملاؤها عام 2006 أن تسعة أنواع فقط من أصل 47 نوعاً من الفطريات التي جمعوها في تشيرنوبل نمت باتجاه مصدر من السيزيوم المشع (السيزيوم-137).
وحدث شيء مشابه في 2022، إذ لم يجد العلماء في مختبرات سانديا الوطنية بولاية نيو مكسيكو أي اختلاف في النمو عند تعريض نوعين من الفطريات – أحدهما يحتوي على الميلانين والآخر لا يحتويه – للأشعة فوق البنفسجية والسيزيوم-137 المشع.
لكن في العام نفسه، ظهر مجدداً الميل نفسه لنمو الفطريات عند تعرضها للإشعاع، لكن هذه المرة، كان ذلك في الفضاء.
على خلاف التحلل الإشعاعي الذي اكتشف في تشيرنوبل، فإن ما يُعرف بـ "الإشعاع الكوني المجرّي" هو عاصفة غير مرئية من البروتونات المشحونة، كل منها يسافر بسرعات تقارب سرعة الضوء عبر الكون.
وينشأ هذا الإشعاع من نجوم متفجرة خارج نظامنا الشمسي، بل إنه يخترق عنصر الرصاص بسهولة نسبية.
وعلى الأرض، يوفر الغلاف الجوي حماية كبيرة لنا منه، لكن بالنسبة لرواد الفضاء المتجهين إلى أعماق الفضاء، فقد وُصف بأنه "أعظم خطر" يهدّد صحتهم.
وحتى الإشعاع الكوني المجرّي لم يكن عائقاً أمام عينات من فطر "Cladosporium sphaerospermum"، أي السلالة نفسها التي اكتشفتها زهدانوفا وهي تنمو في أنحاء تشيرنوبل، وذلك وفقاً لدراسة أُرسلت فيها هذه الفطريات إلى المحطة الفضائية الدولية في ديسمبر/ كانون الأول 2018.

وقال نيلس أفريش، عالم الكيمياء الحيوية في جامعة فلوريدا وأحد المشاركين في الدراسة: "ما أثبتناه هو أنها تنمو بشكل أفضل في الفضاء".
وبالمقارنة مع العينات الضابطة على الأرض، اكتشف الباحثون أن الفطريات التي تعرضت للإشعاع الكوني المجرّي لمدة 26 يوماً نمت بمعدل أسرع بلغ 1.21 مرة في المتوسط.
ومع ذلك، لا يزال أفريش غير مقتنع بأن فطر "C. sphaerospermum" كان يستغل الإشعاع في الفضاء. فهو يرى أن زيادة معدلات النمو قد تكون ناتجة عن انعدام الجاذبية، وهو عامل لم تختبره الفطريات على الأرض.
ويجري أفريش الآن تجارب باستخدام جهاز المحاكاة العشوائية للموضع الذي يعيد خلق ظروف انعدام الجاذبية هنا على الأرض، في محاولة لتمييز أي الاحتمالين هو الصحيح.
واختبر أفريش وزملاؤه أيضاً القدرة الوقائية للميلانين في فطر "C. sphaerospermum" بوضع جهاز استشعار أسفل عينة منه على متن المحطة الفضائية الدولية.
وبالمقارنة مع العينات الخالية من الفطر، ازداد مقدار الإشعاع المحجوب مع نمو الفطر، حتى إن طبقة رقيقة من عفن "بتري" بدت وكأنها درع فعال.
وتوصل الباحثون إلى أنه "بالنظر إلى رقة طبقة الكتلة الحيوية نسبياً، فقد يشير ذلك إلى قدرة عميقة لدى فطر
C. sphaerospermum على امتصاص إشعاع الفضاء ضمن الطيف المقاس".
وقال عالم الكيمياء الحيوية في جامعة فلوريدا إنه لا يزال من الممكن أن تكون الفوائد الوقائية الظاهرة للفطريات ناتجة عن مكونات أخرى في الحياة البيولوجية غير الميلانين.
فالماء - على سبيل المثال - وهو جزيء يحتوي على عدد كبير من البروتونات في بنيته (ثمانية في الأكسجين وواحد في كل ذرة هيدروجين)، يُعد من أفضل الوسائل للحماية من البروتونات التي تنطلق بسرعة هائلة عبر الفضاء، فيما يشبه من منظور علم الأحياء الفلكي مواجهة النار بالنار.
ومع ذلك، فتحت هذه النتائج آفاقاً مثيرة لحل إحدى مشكلات العيش في الفضاء.
إذ تخطط كل من الصين والولايات المتحدة لإقامة قاعدة على سطح القمر خلال العقود المقبلة، بينما تسعى شركة سبيس إكس في ولاية تكساس إلى إطلاق أول مهمة لها إلى المريخ بحلول نهاية عام 2026، مع هدف إنزال البشر هناك بعد ثلاث إلى خمس سنوات.
وسيحتاج كل من يعيش في هذه القواعد إلى حماية من الإشعاع الكوني. غير أن استخدام الماء أو بلاستيك البولي إيثيلين كغلافٍ واقٍ من الإشعاع قد يكون ثقيلاً جداً على الإقلاع.
ويُطرح المعدن والزجاج مشكلة مشابهة. فقد شبّهت لين ج. روثتشايلد، عالمة الأحياء الفلكية في مركز أبحاث أميس التابع لناسا، نقل هذه المواد إلى الفضاء لبناء قواعد فضائية بالسلحفاة التي تحمل صدفتها أينما ذهبت. وقالت في بيان لناسا في 2020 إنه "خيار موثوق، لكنه يأتي بتكاليف طاقة هائلة".
وقاد بحثها إلى تطوير أثاث وجدران قائمة على الفطريات يمكن إنماؤها على سطح القمر أو المريخ.
ولن يقتصر دور هذا النوع من "العمارة الفطرية" على خفض تكاليف الإقلاع فحسب، بل - إذا ثبتت صحة نتائج داداتشوفا وأفريش - يمكن استخدامه أيضاً لتشكيل درع إشعاعي، أي حاجز ذاتي التجدد يحمي البشر في الفضاء من عاصفة الإشعاع الكوني المجرّي في الخارج.
كما استعمرت تلك الفطريات السوداء عالماً مهجوراً في تشيرنوبل، ربما تتمكن يوماً ما من حماية خطواتنا الأولى على عوالم جديدة في أماكن أخرى من النظام الشمسي.
- كيف نجت النباتات من الإشعاع القاتل لتشيرنوبل؟
- ارتفاع حاد في مستويات الإشعاع في تشيرنويل
- عمليات جراحية على نغمات الموسيقى: اكتشاف علمي يغير قواعد التخدير



























































































 شكري بوزيان - محلاك يامي
شكري بوزيان - محلاك يامي